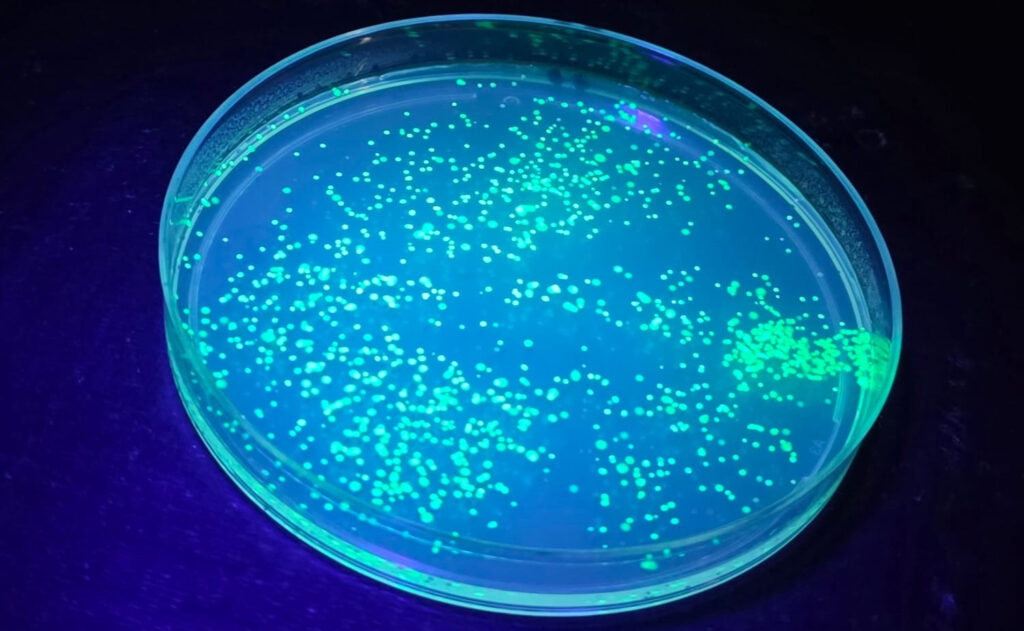
C1

mint

MINT-Förderung an der Schillerschule
Die MINT-Bildung an der Schillerschule ist Teil einer lebendigen und vielfältigen Schulkultur. Sowohl im regulären Unterricht als auch durch ergänzende Projekte und Wettbewerbe bieten wir unseren Schülerinnen und Schülern alltagsnahe und praxisorientierte Einblicke in Mathematik, Informatik, Naturwissenschaften und Technik, die über das reine Fachwissen hinausgehen. Das MINT-Art-Projekt verbindet beispielsweise wissenschaftliche Inhalte mit künstlerischen Elementen und eröffnet neue Blickwinkel auf beide Bereiche. Mit Formaten wie dem „Experiment des Monats“ in der Chemie oder dem „Problem des Monats“ in der Mathematik schaffen wir zusätzliche Angebote, die zum eigenständigen Problemlösen anregen.
Die MINT-Aktivitäten an der Schillerschule eröffnen dadurch Raum für Neugier, Kreativität und Forschergeist – und leisten damit einen wichtigen Beitrag zur individuellen Förderung und zur Vorbereitung auf zukünftige Bildungswege.
Das MINT-Team der Schillerschule
Hinter den vielfältigen Angeboten im MINT-Bereich stehen engagierte Kolleginnen und Kollegen sowie ein ambitioniertes Team aus Lehrkräften (MINT-Team), das sich kontinuierlich für die Weiterentwicklung des MINT-Profils einsetzt. In regelmäßigen Treffen tauschen wir Ideen aus, entwickeln neue Projekte und arbeiten an nachhaltigen Konzepten für einen praxisnahen Unterricht und darüber hinaus.
Unser Ziel ist es, Schülerinnen und Schüler langfristig für Mathematik, Informatik, Naturwissenschaften und Technik zu begeistern. Dabei verstehen wir MINT nicht nur als Wissensvermittlung, sondern auch als Chance, Talente zu entdecken, Interessen zu vertiefen und wichtige Zukunftskompetenzen zu fördern.
Ansprechpartner: Sven Koch, sven.koch[AT]schule.hessen.de
Aktivitäten und Wettbewerbe
An der Schillerschule realisieren wir gemeinsam mit den Schülerinnen und Schülern spannende MINT-Aktivitäten. Dazu gehören beispielsweise zahlreiche Exkursionen in verschiedenen Fächern und Jahrgangsstufen, die fachübergreifende Einblicke ermöglichen und praktische Erfahrungen fördern. Auch Projekte wie der Pi-Day und der Mathesamstag gehören fest zum Schuljahr – zwei besondere Gelegenheiten, Mathematik praktisch zu erleben.
Darüber hinaus beteiligt sich die Schillerschule regelmäßig an naturwissenschaftlichen und mathematischen Wettbewerben, darunter die Junior Science Olympiade und der Mathematikwettbewerb.
Wer sich inspirieren lassen möchte, findet Eindrücke und weitere Informationen in den folgenden Berichten:
MINT-Art
Kunst in der Mathematik erleben oder Naturwissenschaft in der Kunst entdecken – an der Schillerschule wird genau diese Verbindung möglich. An verschiedenen Stellen werden Inhalte aus den MINT-Fächern mit künstlerischen Elementen und den Zielen der Kulturellen Bildung verknüpft. Dabei entstehen kreative Zugänge: Es wird mit Experimenten gestaltet oder die Ästhetik von Symmetrie erfahrbar gemacht – und noch vieles mehr entdeckt.
MINT-Art richtet sich an alle, die gerne über den Tellerrand hinausschauen und neue, fachübergreifende Perspektiven erkunden möchten.
Experiment des Monats (Chemie)
Liebe Schülerinnen und Schüler,
ihr experimentiert gerne und habt Spaß daran, Neues auszuprobieren? Dann ist das „Experiment des Monats“ genau das Richtige für euch! Jeden Monat erwartet euch ein spannender Versuch, den ihr ganz einfach zu Hause durchführen könnt. Dabei habt ihr die Möglichkeit, eure experimentellen Fähigkeiten zu entdecken und weiterzuentwickeln.
Eure Ansprechpartnerin ist Anita Spanuth, anita.spanuth[AT]schule.hessen.de
Wir sind gespannt auf eure Beobachtungen und Ergebnisse!
Hier geht es zu den Experimenten:
Problem des Monats (Mathematik)
Liebe Schülerinnen und Schüler,
für alle, die sich gerne mit mathematischen Aufgaben auseinandersetzen, bietet das „Problem des Monats“ regelmäßig neue Herausforderungen zum Knobeln und Nachdenken. Eine gute Gelegenheit, logisches Denken zu schärfen und neue Lösungsstrategien auszuprobieren.
Eure Ansprechpartnerin ist Aileen Albert, aileen.albert[AT]schule.hessen.de
Viel Erfolg und Freude beim Lösen der Aufgaben!